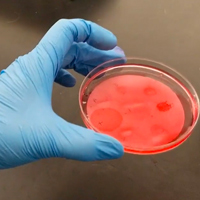

University employees identified ways to adapt during the pandemic by taking on new roles, shifting jobs and making new connections.
 Skip to main content
Skip to main content

University employees identified ways to adapt during the pandemic by taking on new roles, shifting jobs and making new connections.

“Flourishing” will prepare veterans and members of the intelligence community to transition to high-level civilian management positions, while flourishing in their careers and personal lives.

William & Mary’s chapter of the Society of Physics Students put together an impressive slate of fun and educational activities for 2019-2020, and when a pandemic hit, they went virtual, barely breaking stride.

Four community builders will be honored by the university during its 2021 Charter Day ceremony.

With local schools closed for much of the fall semester due to the pandemic, Olwen Herron, superintendent of Williamsburg-James City County Schools, knew that partnering with William & Mary was one way the division could better support their K-5 students during virtual learning.

As we head into the holidays, W&M News spoke with Dr. Elizabeth De Falcon to learn about ways relieve stress and practice self-care over winter break, to strengthen our collective immune systems.

Melissa J. Moore ’84 is the chief scientific officer of platform research at Massachusetts-based Moderna Inc.. She is a key part of the biotech company’s effort to produce 200 million COVID-19 vaccines for the U.S. government to distribute to Americans across the country.

To better understand how politics play out online, W&M News spoke with Jaime Settle, associate professor of government at William & Mary. She is the director of the Social Networks and Political Psychology Lab and her book, Frenemies: How Social Media Polarizes America, was published by Cambridge University Press in 2018.

When the Food and Drug Administration granted emergency use authorization for the first coronavirus vaccine, Operation Warp Speed’s distribution plans sprang into action — and so did two William & Mary alumni.

A bird that since John James Audubon’s time has scurried under the radar of all but the most attentive ornithologists, conservationists and naturalists has received protection from the U.S. Fish and Wildlife Service.

A new two-year grant from the Hewlett Foundation will help AidData bolster engagement with policy makers and influencers in Africa

For the second year in a row, William & Mary alumni Mike Tomlin '95 and Sean McDermott '98 will coach against each other as the Steelers visit Buffalo Sunday night.

Adriano Marinazzo, curator of digital initiatives at the Muscarelle Museum of Art at William & Mary, published his hypothesis that Michelangelo may have carved the figure on a well-known outdoor stone façade in Italy, noting its similarity to a drawing attributed to the artist.

The State Council of Higher Education for Virginia (SCHEV) has selected Pamela Eddy, professor of higher education at William & Mary, as one of 12 faculty members from across the Commonwealth of Virginia to win the 2021 Outstanding Faculty Award.

Lisa Crawford and her video team have helped the university's traditions proceed during the COVID-19 pandemic by going virtual.

The William & Mary Green Fee, established in 2008 by student request, has provided over $1.6 million in funding for sustainability-related projects. This fall, the W&M Committee on Sustainability (COS) awarded Green Fee proposals for seven sustainability-related projects, totaling $24,038.

The idea seems to be gaining momentum among alumni for such reasons as: the opportunity to return to a familiar setting filled with treasured memories from the dawning of adulthood; to enjoy the cultural, recreational and intellectual benefits of living close to a university; and to strengthen bonds with others in the W&M community.

The NCAA released its annual graduation rate reports, and for the 16th consecutive year, W&M led all public schools in the Federal Graduation Rate.

In its first public instruction opportunity, the university’s history writing center will guide middle school and high school teachers and students on the elements of effective historical writing.

On Nov. 11 — Veterans Day, appropriately enough — Merkl took on his latest challenge. He is now special assistant for military & veterans affairs with William & Mary’s Veteran-to-Executive Transition program.

Every student in in William & Mary’s teacher education programs was offered a position teaching in the Newport News Public Schools division for the 2021-22 school year.

When he started at W&M as a freshman with an interest in government, Aidan Gosset ’22 had no idea he’d end up creating his own major focused on education. It soon became his goal as he began taking classes within the interdisciplinary Minor in Educational Studies offered by the W&M School of Education.

Rebecca Green, co-director of W&M's Election Law Program, explains what comes next in the American democratic process.

William & Mary alumna Jen Psaki '00 has been named the next White House press secretary by U.S. President-elect Joe Biden, who will take office in January.

Versatile and interactive, the GIS-driven storymap may become the quintessential communication medium of the 21st century.

Sitting in his hotel room Thursday night, Nathan Knight finally had a chance to decompress. The previous 24 hours had been a blur, one that took him through two excruciating rounds of the NBA Draft before agreeing to terms with the Atlanta Hawks.

Lessons from the fall will help university “flex new muscles” for adapting, teaching and social life amid the COVID-19 pandemic.

Along with peers across the country, Anna Laws ’18 helped launch The FarmLink Project, a nonprofit that transports surplus produce from farms to food banks in need while restoring the jobs of farmers and truckers.

As we head into the holidays, W&M News spoke with Carrie Dolan, an epidemiologist, an assistant professor in health sciences and a member of William & Mary’s Public Health Advisory Board, about ways to enjoy the season safely.

A team of undergraduates at William & Mary has earned high honors in the world’s largest synthetic biology competition for engineering a potential COVID-19 therapeutic.

As part of the sociology department’s Social Justice Policy Initiative at William & Mary, six students are doing internships this semester with three local organizations working in the areas of voter registration, legal redress, educational equity and African-American history.

At a time when social interactions are limited because of the COVID-19 pandemic, one-on-one sessions between students and peer consultants through the Writing Resources Center provide a valuable human connection.

For the third consecutive year, the university received the coveted Higher Education Excellence in Diversity Award from INSIGHT Into Diversity magazine. W&M is featured in the November issue.

Shantá D. Hinton was a pioneer in the study of a group of enzymes known as pseudophosphatases, particularly one known as MK-STYX. Pseudophosphatases were long considered a research dead-end, but Hinton and a handful of other labs discovered that there was nothing pseudo about these proteins.

Shift to new habitat helps fiddler crabs leave some troubles behind.

William & Mary's Branch Out Alternative Breaks adapted to still make a difference, despite the pandemic.

William & Mary has the highest percentage of undergraduates participating in study-abroad programs compared to any other public university in the United States.

As William & Mary prepares to complete the fall semester, the university informed its community about a series of policies and public health measures that will be in place over winter break and the spring semester.

Ghana Smith, a financial system specialist at William & Mary, has been coordinating the Barrett-Peake Heritage Foundation’s restoration project of two Hampton cemeteries for nearly 18 months.

Three annual traditions will be conducted in a new format as William & Mary adapts to public health guidelines to safeguard against COVID-19. Yule Log, Charter Day and winter graduate recognition will all be held virtually, the university announced this week.

Six years ago, Montique Warren, MBA ’14 approached his classmate Stephanie Appiah, JD/MBA ’15 with an idea he had about establishing a networking group for students and alumni of color at the Raymond A. Mason School of Business.

The human brain is hardwired for resilience, to adapt and make sense of the incomprehensible. For members of the military who have served in combat zones, that cognitive plasticity is tested to the limit – and sometimes beyond.

The following books by William & Mary faculty members were published in 2020.

Matthew Allar, associate professor of theatre at William & Mary, completely reworked his Fundamentals of Theatrical Design course for this fall using digital elements

The Garden Club of Virginia has chosen Sarah McGuire Nuss as a winner of its Conservation Educator Award for 2020.

Bryan Watts, the director of William & Mary’s Center for Conservation Biology, and Fletcher Smith, a research associate at the CCB, are part of an effort to share animal-tracking data to get a handle on what is ahead for the diverse animal populations of the changing Arctic and near-Arctic habitats.

University resets process pending gender equity review and financial plan; men’s athletics teams slated for reclassification will continue as Division I sports through at least 2021-22.

The Piney Grove Preserve has shifted from receiving red-cockaded woodpeckers from other populations to donating woodpeckers. The movement marks a milestone in the recovery of the species and is a testament to the valuable work of W&M’s Center for Conservation Biology.

William & Mary alumni, parents, students, faculty, staff, family and friends came together virtually Oct. 12-23 to reconnect with each other and celebrate community.

Bay hypoxia in 2020 was below average due to cool temperatures, wind events and nutrient reductions.

W&M’s Teaching, Research and International Policy Project works overtime to inform public about critical international relations topics in lead up to election.

When people think of the Colonial National Historical Park, they think of, well…history. But it has a feature that goes back even farther than the landing at Jamestown: fossils.

The American Physical Society has named William & Mary physicist Patricia Vahle as a 2020 APS Fellow. Vahle, a professor in the university’s Department of Physics, was nominated by the APS Division of Particles and Fields.

With another Election Day upon us, William & Mary’s Student-Athlete Advisory Committee is doing its part to improve turnout. Behind a department-wide initiative, the SAAC helped register all eligible student-athletes to vote in what, for most, will be their first presidential election.

Amid the chaos of the pandemic, Mark Richard finds stability as William & Mary’s Class of 1939 Artist in Residence

With Election Day less than a week away, Esther Kim, assistant professor of social studies, shares some strategies, tips and resources for educators and parents navigating conversations with children and young adults.

As the race for a COVID-19 vaccine presses on throughout the globe, a team of budding synthetic biologists at William & Mary are researching another equally critical tool in the fight against the novel coronavirus – therapeutics.

Rebecca Green has served as co-director of W&M's Election Law Program since 2008. Her research explores topics such as election administration transparency, redistricting transparency and candidate privacy.

A healthy diet means a healthier you, which also means a healthier planet, right? Well, it’s complicated.

A dedicated group of students, faculty and local residents has spent the better part of the past year equipping the William & Mary community with the information and skills they need to vote in this year’s election.

The Virginia Department of Health has five contact tracers working out of an office just off campus.

As a demonstration of support for William & Mary's commitment to gender equity in athletics, an anonymous alumna has stepped forward with a $1.5 million challenge gift for women's athletics scholarships.

William & Mary Libraries is adding a new space with people who love the outdoors in mind. The Libraries announced it will begin constructing a patio outside of Swem in December.

Researchers with VIMS' long-term survey recorded 13.89 young-of-year striped bass per seine haul in the Virginia portion of Chesapeake Bay during 2020, the 8th consecutive year of average or above-average recruitment.

This fall’s pandemic conditions have brought new challenges as well as discoveries for students participating in the COLL 100 photography class, which Lecturer of Art Eliot Dudik teaches.

William & Mary President Katherine A. Rowe discussed leadership during a pandemic during her latest virtual community conversation Oct. 20 as she hosted Education Dean Rob Knoeppel, Law School Dean A. Benjamin Spencer and Arts & Sciences Dean Maria Donoghue Velleca.

When schools transitioned to online learning in March, ESL and bilingual education teachers adapted instruction to keep students engaged as well as their families.

The university is reinstating Women’s Gymnastics, Women’s Swimming and Women’s Volleyball, which will continue as Division I varsity sports. By reinstating these sports, William & Mary will make significant progress toward achieving equity in participation in 2021-22.

South Sawtooth Lake on Canada’s Ellsmere Island is deep, cold and filled with answers for climate-change scientists.

This fall, as new students began classes at William & Mary for the first time and returning students adjusted to a semester unlike any other, they were joined by three new faces — William & Mary’s new deans of the Arts & Sciences, Law School and School of Education.

Partnership with W&M will be the first of its kind for students in Virginia who will receive scholarships and work together in virtual cohorts prior to their enrollment

In the face of the stress and uncertainty of living through a pandemic, William & Mary has adapted its programs and services to offer expanded mental health and wellness resources.

Potluck dinners are a staple of the true college experience, particularly for international students. When the repercussions of the pandemic hit full force, faculty had to get creative about sharing meals as a community.

John Wells to retire at the end of the academic year, a national search for the next dean and director will be conducted.

From professional football to board game design, William & Mary faculty partake in a wide array of pastimes to get away from the daily grind.

Publicly addressing the William & Mary community for the first time since being named interim athletics director, Jeremy Martin outlined how a financial crisis led to the decision announced Sept. 3 to discontinue seven varsity sports. He also vowed to meet with those affected and listen to any ideas they might have.

All three of William & Mary Professor Joan Gavaler’s dance classes this semester have a mix of in-person and remote students. This has made for challenging, but refreshing, turns in adapting her teaching.

Jeremy Martin knows as well as anyone -- and more than most -- that the next few months will be critical for William & Mary Athletics.

John Swaddle, faculty director at William & Mary’s Institute for Integrative Conservation, and a group of graduate students have published a paper evaluating a new window-film product designed to reduce bird-window collisions.

Project offers blueprint for future efforts to maintain & restore coastal habitats.

Persons in the W&M community who have either tested positive or come into close contact with someone who has are assigned case managers to become the main point of contact for any issues or questions that arise.

A rash of deer deaths in the College Woods is likely the result in an overabundance of biting midges, according to Randy Chambers, director of William & Mary’s Keck Environmental Laboratory.

Dr. Lisa A. Jackson ’84 has conducted numerous vaccine studies, but the task before her in March was different — the timing compressed, the stakes higher — when her team launched one of the first human clinical trials for a vaccine to block infection from the virus that causes COVID-19.

Ever since COVID-19 forced their voices and instruments apart in March, William & Mary musicians have been finding ways to bring them back together for virtual audiences.

Dan Cristol is the co-editor of a special issue of the journal Ecotoxicology, along with David Evers of the Biodiversity Research Institute.

As clinical associate professor and director of pre-collegiate learner programs at the Center for Gifted Education, Mihyeon Kim’s influence goes far beyond the instruction she gives in the School of Education’s classrooms.

The funds, along with a bridge grant of $50,000, will establish permanent support for the Osher Institute at William & Mary.

Construction on William & Mary’s new performing arts facilities is continuing this fall after being delayed early in the calendar year due to unforeseen increases in construction costs.

During Friday’s Board of Visitors meeting, William & Mary’s rector and president announced a path forward to rebuild trust and open dialogue with the community following the recent announcement to eliminate seven varsity sports programs.

William & Mary’s Board of Visitors today adopted a set of principles and imperatives for the naming and renaming of structures and spaces on campus.

As the pandemic continues, teachers across the country — at all levels — are conducting their classrooms online. For those who work in special education, it’s been particularly challenging.

What’s it like to see William & Mary from both sides of the classroom — as a student and then as a faculty member? We spoke with alumni faculty members to see what it's like to come full circle.

Morgan, W&M's associate director for faculty personnel services in Arts & Sciences, received the Charles and Virginia Duke Award, which honors exemplary service to the university by someone who is not a student or instructional faculty member.

W&M Assistant Professor Mackenzie Israel-Trummel, who teaches a course on survey and polling analysis, says predicting the election outcome could be difficult under current circumstances.

An expanded first-floor study area at Swem Library will provide ample study space for students, even under current physical distancing guidelines.

What’s Homecoming without, well, coming home to campus? It’s a new opportunity to bring the beloved tradition directly to the William & Mary community, wherever that community may be.

William & Mary offers some of the most exceptional undergraduate teaching in the country and boasts a higher alumni giving rate than any other public university, according to a report released today by U.S. News and World Report.
William & Mary’s STEM faculty across several departments have some up with a variety of creative — and even ingenuous — solutions to conducting lab sections in a pandemic.

In her award-winning paper, W&M student Megan Hogan ’21 examines the use of deepfake technology as a form of national defense. Now she plans to combat disinformation during the 2020 Presidential election.

Early in her career as a William & Mary student, Beulah Elizabeth Cox turned in a physics exam that contained what became one of the most famous incorrect answers in science.

This summer, as educators around the world prepared for teaching a fall semester remotely amid pandemic, faculty from William & Mary’s Data Science program already had a head start – or rather, a jump start.

University will move swiftly in the event positive cases occur within the university community.

Ryan Chaban was one of six graduate students and postdoc fellows selected for the inaugural Commonwealth of Virginia Engineering and Science (COVES) Fellowship.

In what it termed a “wrenching decision” that will impact 118 student-athletes and 13 coaches, William & Mary on Thursday announced the discontinuation of seven varsity sports after the 2020-21 academic year comes to an end.

Ciara Curtin ’24 and Dolly Lebow ’24 met through a unique connection before starting their first semester at William & Mary

Safety, wellness and inclusion are top priorities as in-person undergrad classes begin Sept. 8.

Despite the pandemic, W&M students may still find ways to engage and connect while on campus this semester.

Dena Bashri ’20 and Shivani Gupta ’20 graduated from William & Mary to become two of the six inaugural fellows working remotely for Transforming Primary Care on projects such as ensuring telehealth access to those experiencing homelessness and tracking the supply chain of COVID-19 testing kits.

William & Mary has introduced two new programs emphasizing the theme of service.

The William & Mary community responded “emphatically and with a great deal of warmth toward our Alma Mater of a Nation” to principles drafted for naming and renaming of buildings, spaces and structures on campus.

The Board of Visitors heard updates on the opening of the fall 2020 academic year and approved measures to help W&M weather the COVID-19 pandemic.

William & Mary has launched an online dashboard to keep the community informed about the university’s return-to-campus COVID-19 testing results.

Using a new online platform, performers from the William & Mary community will unite with various artists from across the country to honor giants of social justice.

A finalized design concept for the Memorial to the African Americans Enslaved by William & Mary was presented to the Board of Visitors Tuesday.

The site of one of America’s oldest churches founded entirely by free and enslaved Black people may soon be unearthed. A community-supported excavation aims to find the church’s first permanent structure.

William & Mary Law School’s Virginia Coastal Policy Center (VCPC) is undertaking a project with the Albemarle-Pamlico National Estuary Partnership (APNEP) to increase engagement among tribal communities, government agencies, and universities.

For the past seven years, Dorothy Ibes has been using William & Mary’s outdoor space as a laboratory to understand the relationship between human health and human access to nature.

Linguistics was administered previously as an interdisciplinary program at William & Mary, but now it stands alone as a field of study.

William & Mary kicked off the 2020-2021 academic year Aug. 19 with an online ceremony featuring words of welcome from administrators, alumni and students.

Starting in spring 2021, the program will cover more topics and offer more options for students and faculty members.

As William & Mary celebrates the opening of the academic year, the university will honor a student and staff member for their community service.

William & Mary students and faculty have formalized and expanded several programs focusing on equity issues in the local community, and added new ones, with the establishment of the Social Justice Policy Initiative in the sociology department.

University staff works diligently to make First-Day Move-In special despite unusual circumstances.

As William & Mary begins welcoming students back to campus, the university is implementing enhanced cleaning and disinfection protocols to reduce the likelihood of the spread of infection from COVID-19.

Daniel Borrus began his Ph.D. research at William & Mary with what he thought was going to be an easy experiment, just to get his feet wet in neurophysiology research.

William & Mary’s Principles of Naming and Renaming Working Group is seeking feedback on design imperatives and principles it has drafted around the naming and renaming of buildings, spaces and structures on campus.

William & Mary's Washington Center students persevered to complete meaningful internships in a remote format.

Summer 2020 looked and felt different because of COVID-19 restrictions, but William & Mary students doing research projects using Honors Fellowships thrived amidst change.

As the fall semester grows close, staff members at William & Mary Libraries feel prepared to safely reopen and operate through the uncharted waters of a pandemic.

The freshman class will include 1,559 students selected from a pool of 14,202 applicants. Additionally, W&M will welcome 202 new transfer students this fall.

As William & Mary prepares to bring students back to campus for the fall semester, the university is focused on the task of establishing new social norms in response to COVID-19.

William & Mary led a collaboration with universities throughout Virginia to develop a virtual tool to support the health and wellness of students, faculty and staff this fall.

Anna Mroch, W&M director of planning and assessment, has turned some 48 spools of thread and 102 yards of fabric into more than 1,300 face masks that were distributed to those in need throughout 10 states.

The William & Mary website is getting a new homepage, updated menus and search function and refreshed page designs — the first steps in outfitting the university with better, more flexible and varied tools with which to build webpages.

Inventorying every space on William & Mary’s campus, and then applying physical distancing regulations onto new and converted instructional spaces, has taken cooperation from departments far and wide.

William & Mary is among the top public universities in the nation that give students the greatest return on investment, according to a new ranking from CNBC.

Epidemiologist Erica E. Smith ’08 helps coordinate Delaware’s response to COVID-19

A postdoctoral researcher in the Department of Physics at William & Mary, Wenliang “Bill” Li is studying proton structure — just like many people who conduct their nuclear physics research at Jefferson Lab. But he’s studying a new aspect of it: the backward perspective.

As William & Mary prepares for the start of the academic year during a pandemic, the university released Monday a statement of expectations – and a commitment to each other – for everyone planning to live, work and study together on campus this fall.

William & Mary recently announced a series of campus safety protocols for the fall semester.

Gérard Chouin, associate professor of history at William & Mary, discusses COVID-19 in the context of past pandemics.

William & Mary completed its boldest fundraising campaign yet, with $1.04 billion raised, ties among alumni and alma mater strengthened and its status as the No. 1 public university for alumni participation cemented several years in a row.

Expanded health care for students to include general care support, mental health services and comprehensive orthopedic and sports medical coverage

Find your next “must read” in the quarterly book roundup of titles written by W&M alumni and faculty.

With COVID-19 numbers again on the rise, William & Mary on Friday took the unprecedented step of postponing its fall athletic season.

W&M Professor Jack Martin used time at home during the COVID-19 pandemic to finish a revised Choctaw dictionary that was four years in the making.

A William & Mary mathematician and an undergraduate student are part of a team that has developed an interactive, user-friendly dashboard tracking COVID-19 infections and deaths across the U.S.

During a virtual meeting July 15, William & Mary administrators, faculty, students and staff updated the Board of Visitors executive committee on the university’s financial position, inclusion and equity efforts and plans for fall.

Thanks to a $10 million gift from an anonymous alumna who serves as a trustee of the William & Mary Foundation, the university is developing a cutting-edge Veteran-to-Executive Transition program that will prepare veterans to excel in civilian leadership roles.

When William & Mary Football Coach Mike London shares his thoughts on race relations and the police, he speaks from experience.

As Americans make efforts to learn more about the social justice and racial equity issues that are front and center in the nation right now, William & Mary Libraries has joined other institutions around the country in providing resources for self-education.

W&M economics Professor Nathaniel Throckmorton recently contributed to a study that examines the impact of the COVID-19 pandemic on the country’s labor force.

AidData, a research lab based at William & Mary’s Global Research Institute (GRI), has been building a new dataset that sheds light on China’s vast portfolio of grant- and loan-financed projects around the globe.

Hundreds of William & Mary alumni, all over the world, work in the wine industry, from growing grapes to making wines to managing wineries to marketing, sales and distribution.

Just after 9/11, Michael London Jr., was patrolling the Persian Gulf on the USS Sacramento. Today, he is out of the service and part of William & Mary's athletic department as an assistant football coach.

William & Mary recently released a series of updates about its plans for the fall semester. The updates contain new details about remote learning and work, physical distancing and safety measures, fall course offerings and planned use of space on campus.

As COVID-19 and stay-at-home orders upended life as we know it, W&M chemist Rachel O’Brien turned her kitchen into a makeshift laboratory. She and her lab students literally cooked up experiments in their homes by measuring aerosols released during cooking.

As the first woman to become president of the National Outdoor Leadership School, Terri Watson ’85 brings nearly three decades of experience in corporate and nonprofit roles to an organization that enrolls more than 25,000 students annually in programs around the world.

Chinua Thelwell discusses his new book "Exporting Jim Crow: Blackface Minstrelsy in South Africa and Beyond” and continuing efforts to remove blackface imagery from American culture.

A working group of administrators, alumni, students, faculty and staff will develop principles on the naming and renaming of buildings, spaces and structures at William & Mary.

This is a tale of two yeasts. Well, actually, three yeasts.

Jason Chen, Gerdelman Family Term Distinguished Associate Professor at the William & Mary School of Education, has secured a new grant from the National Science Foundation that aims to combat inequity by building a national alliance of researchers working together to effect large-scale change.

Faculty with William & Mary’s Center for Geospatial Analysis instill graduate and undergraduate students with the skills and understanding to use mapping and visualization techniques in projects ranging from art history to field biology.

William & Mary's geology department is going ahead with field work this summer, heading to their outcrops and fossil beds armed with more than their rock hammers. Faculty mentors have come up with an evolving set of creative ways to maintain social distance.

As a student, Moesha Parsons ’20 founded Minorities in Medicine, a student organization for pre-med students of color. Though she has graduated, the organization will continue to support future students like her.

David Brashear was named director of the Muscarelle Museum of Art at William & Mary, university officials announced.

William & Mary’s decision in early March to move all classes to a remote format in response to COVID-19 gave the newly created Studio for Teaching & Learning Innovation an urgent purpose: Help faculty and students complete the semester.

Samuel Hayes III, a professional engineer and management consultant, has been selected to lead William & Mary’s facilities management department as interim chief facilities officer beginning July 1.

The following people will be recognized June 19, 2020, for reaching milestones in their years of service to the university.

Robert C. Knoeppel, dean of the University of South Florida’s College of Education, longtime educator and noted scholar on educational finance innovation, has been chosen as the next dean of William & Mary’s School of Education.

The W&M Board of Visitors Tuesday approved the use of temporary personnel actions, including furloughs and pay reductions, if needed for the upcoming fiscal year.

Things are going to be different this fall in the core labs of William & Mary’s Applied Research Center. What won’t change is the dedication of the ARC staff to the research mission of the university and the commonwealth.

William & Mary was featured in a segment on “60 Minutes” June 14 that explored how universities nationwide are working to reopen this fall during the greatest pandemic in 100 years.

In response to the COVID-19 pandemic, William & Mary will have an in-person fall semester that starts early and ends before Thanksgiving, President Katherine A. Rowe announced in an email today.

W&M’s Ariel BenYishay contributes expertise in geospatial impact evaluation to a land titling paper recently published in the journal Nature Sustainability.

The geoBoundaries database is the product of three years of work by a group that consisted substantially of William & Mary undergraduates and recent alumni.

William & Mary community members from near and far joined together in a virtual candlelight vigil Tuesday evening.

A team of W&M researchers is conducting an online survey on how families are coping during the COVID-19 pandemic, and offering resources on what parents can do to support their children’s mental health.

As an officer with the Centers for Disease Control and Prevention, Megan L. Casey ’04 evaluated hospital and clinic infection control practices in Sierra Leone during the Ebola outbreak in 2014. Now she's taking her expertise stateside.

Former Va. chief deputy A.G. succeeds Warren Buck, who transitions to advisory role

Philosophy faculty member Philip Swenson and Dustin Crummett ’12 were never at William & Mary at the same time, but their connection has now been forged in print by the publication of their co-authored paper.

William & Mary News spoke remotely with Amy Sebring, vice president for finance & technology, to talk about how the university is confronting the financial challenges presented by COVID-19, and what to expect in the coming months.

The inaugural Raymond A. Mason School of Business Data Feast competition challenged teams of business analytics graduate students to test their technical and business acumen skills using real data.

Art from Sybil Shainwald '48, LL.D. '19 will expand the collection of the Muscarelle Museum of Art at William & Mary.

The Social Justice & Diversity Research Fellowship Program, now in its third year at William & Mary, aims to equip students to address issues of inequity in academia, in their professions and in their everyday lives.

William & Mary Associate Professor of Sociology Deenesh Sohoni and Yosselin Turcios ’20 researched the deportation of U.S. military veterans who are non-citizens throughout Turcios’ four years at William & Mary and have had their paper accepted for publication.

A team of three William & Mary undergrads hit the back of the net this spring, scoring top honors in an international mathematics competition with their analysis of soccer team strategies.

The upheaval and restrictions of COVID-19 won’t stop undergraduate research over the summer at William & Mary. But prudence and social-distancing measures will make the experiences quite a bit different from previous years.

For the 2019-20 athletic season, which ended prematurely on March 12 due to the coronavirus outbreak, W&M had five of its mentors named Coach of the Year in the Colonial Athletic Association. Two more were honored by the Eastern College Athletic Conference.

Species shows resilience despite general decline in abundance

Caylin Carbonell, a Ph.D. candidate in history at William & Mary, is completing a dissertation on New England households that challenges longstanding historiographic trends and reconsiders how to document the past.

Rogers '20 graduated Saturday and was elected to the Williamsburg City Council on Tuesday, putting his public policy degree to immediate use.

Inspired by the help and support he received from complete strangers, Michael Porath ’97 founded The Mighty, a digital health community aimed at empowering and connecting people who face health challenges and disabilities.

A team at the DIII-D National Fusion Facility led by a William & Mary physicist has made a significant advancement in physics understanding that represents a key step toward practical fusion energy.

Jonna Reinhardt ’07, M.B.A. ’20 served 10 years as an Army Ranger before returning to W&M. He was recently commissioned as a second lieutenant.

The Nicolas and Valentine Boël Endowment for International Business will enable Dean Larry Pulley to invest strategically in programs that cultivate a global mindset among undergraduate and graduate students.

Heather Kenny, a biology master’s student at William & Mary, has spent the past two years studying the parenting behavior of bluebirds. Specifically, she is working to understand how human-made noise influences nesting and productivity.

The seven alumni are among more than 2,100 U.S. citizens who received the Fulbright U.S. Student Program award in 2020. The prestigious award provides students the funding they need to study, research and teach abroad.

A. Benjamin Spencer, a nationally renowned civil procedure and federal courts expert and current professor of law at the University of Virginia will begin at William & Mary Law School July 1.

Patricia “Patti” Jarboe Dwyer has been nominated by her peers and selected by the W&M Alumni Association Board of Directors to be inducted as an honorary alumna.

William & Mary’s Class of 2020 received words of encouragement and advice from not just one Commencement speaker this year, but many as the university hosted its first virtual degree-conferral ceremony.

William & Mary’s Board of Visitors voted Tuesday to re-elect John E. Littel P '22 as rector and William H. Payne II '01 as vice rector of the governing body of the university. Additionally, Barbara L. Johnson J.D. '84 was elected as secretary of the board.

To help Virginia’s small businesses during the pandemic, Pete Snyder ’94 and his wife Burson Snyder created the nonprofit Virginia 30 Day Fund.

Patrick Abboud ’20 is looking at his world through new eyes this spring.

Several awards are presented annually to graduates, staff and faculty members during the William & Mary Commencement ceremony.

Senior students join W&M President Katherine A. Rowe's Community Conversation to talk about Saturday's virtual conferral ceremony and life after graduation.

On May 16, William & Mary will mark the day that was previously reserved for this year’s Commencement exercises with its first-ever virtual conferral ceremony. The university plans to celebrate 2020 graduates in-person in the fall.

William & Mary will make standardized test scores optional for undergraduate applicants in the 2020-2021 admission cycle under a new three-year pilot program that responds immediately to difficulties high school students are facing in scheduling the standardized tests.

The William & Mary Board of Visitors unanimously voted Tuesday to roll back a previously adopted tuition increase for incoming in-state undergraduates and keep tuition and mandatory fees flat for all students, including in-state and out-of-state undergraduates, graduate and professional students.

Most students hope for an A for their midterm projects. Thomas Vandiver ’13 got a whole business from his.

The William & Mary Committee on Sustainability has announced the spring 2020 Green Fee awards, which will be awarded to seven campus projects.

Bit by bit, byte by byte, artificial intelligence has been working its way into public consciousness and into everyday computer use.

Persons within and outside the William & Mary community have donated an assortment of works to document what life has been like during the COVID-19 pandemic.

Francis Tanglao Aguas had wanted to stage “Rolling the R’s” for years and never could have imagined the circumstances under which he would do so.

The William & Mary community celebrated Earth Week virtually this spring, working with other Virginia universities to offer events accessible to the public through multiple online platforms.

For the faculty and staff of the Lewis B. Puller, Jr., Veterans Benefits Clinic, it was all hands on deck when William & Mary Law School closed its building during the COVID-19 shutdown.

Uncertainty and new ways of doing things can be shifted into positives, according to a William & Mary group discussion May 6 about turning challenges brought on by COVID-19 into opportunities for innovation.

Greater tropical rainfall may increase microbes’ release of CO2 from soils into air, according to a study conducted by an international team led by Dr. Christopher Hein of William & Mary’s Virginia Institute of Marine Science.

Having completed a month-long mission of helping New York City hospitals that were overwhelmed by the coronavirus pandemic, the USNS Comfort has sailed back to Virginia with about 600 doctors, nurses and other crew members, including Dr. A. Scott Morris ’10, a lieutenant in the Navy’s Medical Corps and an alumnus of William & Mary.

The International Students, Scholars and Programs staff at William & Mary has been focused on the well-being of W&M's international students and scholars — both in Williamsburg and overseas.

At a time when more than 30 million Americans have filed for unemployment benefits as a result of the COVID-19 pandemic, William & Mary’s career development leaders are collaborating to share information and leverage resources across different departments and schools.

CBS News White House Correspondent Weijia Jiang '05 recently joined David Culver ‘09, an international correspondent for CNN, for a special installment of President Katherine A. Rowe’s Community Conversation series.

Jessica Johnson, visiting assistant professor of religious studies at William & Mary, has covered quite a bit in her two courses this spring: new religious movements in America and a new one — gender, sexuality and religion in America.

In his 20 years as president and CEO of the L.A. Regional Food Bank, Michael Flood '84 has seen earthquakes, wildfires and flooding. But nothing that compares to a global pandemic.

Some William & Mary students elected to return to Williamsburg to serve at area hospitals as EMTs and scribes.

Back in February, virologist Kurt Williamson answered questions about COVID-19 when the outbreak was beginning to spread. We asked him to take another look at the coronavirus pandemic.

A new gift to W&M will support graduate students working in the New Horizons Family Counseling Center, which assists families of students in local public schools who are facing difficult times, and the New Leaf Clinic, which provides counseling to community members struggling with substance abuse.

W&M Athletics's Chief Medical Officer, Director of Medical Service and team physician for the Tribe, Dr. Virginia Wells shares advice for combating infectious disease.

William & Mary Libraries has launched a Textbook Affordability Initiative on campus to address the rising costs of textbooks.

William & Mary students left campus to return to their homes because of COVID-19, but many of them have found a way to reach back and connect to the place they also consider home.

Technological advances are allowing archaeologists to take a wider, yet closer, look at ancient sites, opening up long-hidden evidence about the societies of the people who lived there.

The Executive Committee of the William & Mary Board of Visitors met today virtually to hear presentations and updates by President Katherine A. Rowe and senior leadership on the university’s response to the COVID-19 pandemic.

This spring, the Law School’s English Bridge students happen to all be from China. The coronavirus is keeping the students in quarantine, so it may be that this online class is the one thing in their lives that hasn’t been disrupted since the outbreak.

The university is working to minimize its expenditures and focusing on things that are mission critical.

In early February, while most Americans were still going about their usual daily routines, Dr. Jennifer Primeggia ’02 and her fellow physicians working in infectious diseases at Virginia Hospital Center near Washington, D.C., were preparing for an influx of patients with COVID-19.

As soon as Vitoria Okuyama returned to her family's home in Brazil, she checked into the master bedroom. For the next two weeks, those four walls would be her self-quarantine chamber.

The beam is off, but high energy physics research is very much on at one of the world’s premier particle physics labs —and William & Mary physicists are among those monitoring the still-active NOvA neutrino detectors.

Through a new virtual tutoring program, student teachers in William & Mary’s elementary education program are providing individualized instruction and support for up to 150 elementary-aged children who are learning at home during the pandemic.

A new study by Zach Conrad, assistant professor in William & Mary’s Department of Kinesiology & Health Sciences, finds that the average American consumer spends roughly $1,300 per year on food that ends up being wasted.

Two decades or so before the great California gold rush, there was a smaller, but still considerable, excitement surrounding the precious metal in Georgia.

The Global Innovation Challenge recently was held entirely over online communications platforms.

W&M education faculty have quickly put together webinars and an at-home learning hub full of resources and tips for parents helping K-12 students at home while schools are closed for COVID-19.

This week’s conversation focused on admission and enrollment challenges during the pandemic.

William & Mary's gymnastics program has approximately 50 of its graduates in the medical profession, many on the front line against this global pandemic. Four of them were willing to take a few minutes out of their hectic days to discuss their work and how it's changed in the last several weeks.

William & Mary to ring Wren Bell and hold a moment of silence on April 16.

More than 50 students opted to donate their housing and dining rebates and parking refunds back to William & Mary in support of students in need, contributing a total of more than $30,000.

Grace Kier ’20 has received a scholarship from the James C. Gaither Junior Fellows Program at the Carnegie Endowment for International Peace.

Two first-year M.B.A. students at William & Mary’s Raymond A. Mason School of Business are organizing efforts to connect small businesses in the Williamsburg area with crisis support and services, free of charge, to aid in their recovery.

The William & Mary alumnus will celebrate a century of life on Sept. 8.

It was a classic case of matching surplus with demand. Only this time it was caused by crisis.

For her research into the underlying neurobiology of attentional processing in the context of schizophrenia drug discovery, Eden Maness is the recipient of the William & Mary Graduate Studies Advisory Board Award for Excellence in Scholarship in the Natural and Computational Sciences.

One of many things that the COVID-19 pandemic will be remembered for is the introduction of the term “social distancing” to the global lexicon. For bird behaviorists, the term and its variants have been in use for over a century.

Students across the country are finishing their spring semesters online while adjusting to social distancing — and athletes are finding new ways to stay active.

Now that the William & Mary community has seen that COVID-19 will affect many things this spring semester, adapting to living and working in the world it has created is next — that was the takeaway from the university’s latest community conversation.

Kay Floyd, director of William & Mary's Whole of Government Center of Excellence, is an expert on interagency cooperation and coordination to solve problems. She says COVID-19 is the ultimate test of the “Whole of Government” approach.

Edward Aractingi has been selected as William & Mary’s next chief information officer and will begin at the university June 10.

The research lab of Patty Zwollo, an immunologist and professor of biology at William & Mary, has discovered that just as whales swallow plastic thinking it’s food, some cellular components of the immune system in fish “swallow” bits of microplastic that they mistake for invading pathogens.

Carrie Dolan, kinesiology and health sciences professor at William & Mary, has a unique perspective on being a student during a crisis and having to leave campus behind.

Professors examine best practices for online instruction and students consider new habits for learning, all the while considering the unique challenges that everybody is facing.

Yoga, meditation, knitting therapy and other wellness activities are still available for members of the William & Mary community.

Emergency funds support W&M students and faculty during the COVID-19 outbreak.

Adwait Jog, an assistant professor in William & Mary’s Department of Computer Science, is working to make computers more efficient by improving the architecture of the machines, necessary for computational handling of projects ranging from machine learning to genomics.

Rowe and special guests speak of healthy ways to deal with the stress and uncertainty that have risen so quickly during ongoing COVID-19 crisis.

An entrepreneurial, engineering-based mindset allowed one William & Mary class to make a real contribution to the fight against the COVID-19 pandemic during its second week of online instruction.

Some good news: The eagle population of the James River alone has exceeded the repopulation goal for the entire Chesapeake Bay.

Michelle Lelièvre, associate professor of anthropology and American studies at William & Mary, was recently named a Frederick Burkhardt Fellow by the American Council of Learned Societies.

Valuable learning opportunities arise even from a crisis and they will shape the way forward, William & Mary President Katherine A. Rowe said during a virtual community conversation broadcast from the President’s House on March 27.

Technology will help W&M students finish the school year. It's also how the Tribe's 18 head coaches and their staff will stay in touch with their athletes.

Specializing in game play and how it helps us with communication, William & Mary Senior Lecturer of Speech Michele King makes playing board games part of her students' classroom experience.

Jeremy Pope, associate professor of history and faculty affiliate in classical studies, has created a unique opportunity for students to learn the Egyptian language at William & Mary.

William & Mary’s move to modified academic operations is prompting departments to look into alternative ways of conducting dissertation defenses of Ph.D. candidates.

A group of William & Mary students has volunteered to deliver hot meals and shelf stable food through Williamsburg Area Meals on Wheels.

If Leah Shaw gets any time to herself during this period of social distancing, she plans to run a simulation — on social distancing.

As a research lab of the university’s Global Research Institute, AidData facilitates innovative research projects that bring students and faculty together to solve global problems.

The staff at William & Mary’s Osher Lifelong Learning Institute found themselves in a bit of a quandary as guidelines for social isolation were announced during the COVID-19 outbreak.

With panic buying affecting grocery stores throughout the country, we spoke with Zach Conrad, assistant professor in the Department of Kinesiology & Health Sciences, to discuss ways to food shop effectively.

William & Mary will offer waitlisted applicants a guaranteed pathway to admission next spring if they either complete a semester at a two-year college or participate in a fall-semester program abroad with Verto Education, which offers immersive international experiences with academic credits.

Kelly Crace, William & Mary’s associate vice president for health & wellness, talks about ways people can cope and take care of themselves during this time of heightened stress.

Maria Donoghue Velleca, an accomplished scholar and award-winning educator who served as senior associate dean for faculty affairs and strategic planning at Georgetown University’s College of Arts & Sciences, has been selected as William & Mary’s dean of the Faculty of Arts & Sciences, President Katherine A. Rowe announced today.

The COVID-19 closings will have a substantial effect on human-subjects research at the university.

The State Council of Higher Education for Virginia has approved William & Mary’s proposal for a new bachelor of science degree in data science.

As William & Mary students and faculty prepare to move temporarily to remote learning, the newly-established Studio for Teaching & Learning Innovation has set up a support system to assist faculty.

Peter Atwater, founder of Financial Insyghts and an adjunct professor of economics at William & Mary, says things are likely to begin to trend upward again.

William & Mary continues to take steps to safeguard the campus community against COVID-19 and participate in the national effort to slow its spread.

It was the first day of class, and Beverly Sher had a question for the William & Mary freshmen enrolled in her Emerging Diseases class. “I asked, ‘Have you guys been reading about this coronavirus?’”

Following her CAA Rookie of the Year season, Eva Hodgson has made history as a sophomore as the Tribe heads into CAA tournament play March 11-14 in Elon, N.C.

For the first time in 35 years as a member, William & Mary has the Colonial Athletic Association's Player, Coach and Defensive Player of the Year.

In December 2019, William & Mary’s Office of Academic Advising received thrilling news.

William & Mary's 2020 Raft Debate will be held in the Sadler Center's Commonwealth Auditorium March 19 at 6:30 p.m.

Jon Kay, a visiting assistant professor of geology at William & Mary, is using the hypothetical situation Matt Damon’s character finds himself in — being stranded on Mars and forced to grow his own food — as a real research question for students in his new COLL 150 class Science and Science Fiction.

William & Mary will be the No. 2 seed in the CAA men's basketball tournament to be played March 7-10 in Washington, D.C.

Mellody Hobson, former chair of DreamWorks Animation and a nationally recognized voice on financial literacy, will speak at William & Mary’s 2020 Commencement ceremony, slated for 8:30 a.m. May 16 in Zable Stadium.

The 19th annual Graduate Research Symposium will be held in the Sadler Center at William & Mary March 20-21.

In the fall, William & Mary Libraries received a valuable collection of comic books and other graphic arts depicting African Americans, donated by Richard Percy Wright, an avid collector who lived in Williamsburg, Virginia.

A persistent mystery surrounding one of William & Mary’s most treasured possessions apparently has been solved, by a 19-year-old sophomore.

At the peak of his college basketball career and in crunch time of his senior season, Nathan Knight ’20 can’t help but relay the enthusiasm he has brewing about William & Mary’s squad.

In the first direct probes of the core of the nuclear interaction, researchers find that leading theories on interactions between protons and neutrons describe them well, even in conditions where the protons and neutrons strongly overlap, such as in neutron stars.

William & Mary alumni, parents and faculty have played a role in addressing the nation’s most lethal public health crisis since the HIV/AIDS epidemic in the 1980s.

William & Mary students, scholars and community members gathered Jan. 31 to celebrate the launch of the International Justice Lab at the university with a roundtable discussion on “International Law and Justice: Challenges and Challengers in the 21st Century.”

The William & Mary men's swimming team won its sixth consecutive Colonial Athletic Association championship on Saturday night, doing so in record-setting fashion in a week filled with individual event records.

Professor Rob Hale of William & Mary’s Virginia Institute of Marine Science is lead author of a new “Grand Challenges” paper commissioned to mark the 100th anniversary of the American Geophysical Union, the world’s largest association of Earth and space scientists with more than 60,000 members in 137 countries.

For the fifth time since 2014, William & Mary was recognized as one of the Most Promising Places to Work in Student Affairs in 2020 by Diverse: Issues in Higher Education.

William & Mary Police Chief Deborah Cheesebro elected president of the Virginia Association of Campus Law Enforcement Administrators.

William & Mary’s 10th annual Lemon Project Spring Symposium will center on the theme of “When and Where They Enter: Four Centuries of Black Women in America.”

Millie West had a significant impact on influence on W&M athletics.

After transferring to William & Mary, Andy Van Vliet ’20 is playing a key role on a team in title contention making a stretch run to post-season play for the first time in his college basketball career.

William & Mary is partnering with the York-James City-Williamsburg NAACP, the City of Williamsburg and others to host the area’s inaugural Juneteenth celebration, which commemorates the end of slavery in the United States.

Dozens of people shared their personal stories about ability and disability Feb. 13 during the first session of this year’s Daily Work of Justice series.

Kurt Williamson is a virologist, an associate professor in William & Mary’s Department of Biology who specializes in the study of viruses. He offers some scientific context for the ongoing COVID-19 outbreak.

Sam Jones ’75, M.B.A. ’80, senior vice president for finance and administration, will step down from his current role at the end of June on his way to retirement.

University and city officials explore new and innovative areas of collaboration at Feb. 12 strategic planning forum.

A joint Australian-U.S. team reveals that one group of seagrasses, Australian species of the genus Posidonia, has evolved yet another remarkable adaptation for ocean survival: a winged seed whose shape harnesses the force of underwater currents to hold it on the seafloor for rooting.

The newly established Health Emergency and Resources for the Tribe — or HEART — Fund provides vital funds that serve students in meaningful and transformative ways.

Undergraduates working in a lab inside the Integrated Science Center are currently studying ways to foster constructive dialogue in an era of increased partisan divide.

Leandra Parris, assistant professor of school psychology at William & Mary, has developed the first scale to measure social media rumination in adolescents.

William & Mary computer scientist Evgenia Smirni has been elected to the 2020 class of fellows of the Institute of Electrical and Electronics Engineers.

Sociology Professor Jennifer Bickham Mendez and Katherine Barko-Alva, assistant professor of English as a second language/bilingual education, continue to find ways to work together and help each other across disciplines.

U.S. Sen. Tim Kaine (D-Va.) LL.D. ’06 Kaine and Chancellor Robert M. Gates ’65, L.H.D. ’98 spoke about their personal journeys as public servants, learning from the past to shape present-day foreign policy and the future of U.S. leadership in a rapidly changing world.

As William & Mary celebrated its history Friday, President Katherine A. Rowe asked the community to use the past to help shape the university’s future through the strategic planning process.

W&M senior lecturer Bella Ginzbursky-Blum was awarded the 2019 Excellence in Teaching (Post-Secondary) Award from the American Association of Teachers of Slavic and East European Languages.

William & Mary is recognizing Black History Month with a number of events, beginning this Friday.

Yusef Salaam spoke at William & Mary’s 2020 Martin Luther King Jr. commemoration before a crowd of faculty, staff, students and community members who filled the Sadler Center’s Commonwealth Auditorium.

The annual update of their sea level “report cards” by researchers at William & Mary’s Virginia Institute of Marine Science adds evidence of an accelerating rate of sea-level rise at nearly all tidal stations along the U.S. coastline.

The Alumni Medallion is the highest and most prestigious award given by the Alumni Association. Meet our 2020 recipients, who represent outstanding dedication, commitment and assistance to William & Mary; exemplary professional accomplishments; and leadership in civic engagement.

The subcommittees' white papers and a reading list will be under review and refinement by the W&M community for the next four to six weeks before being integrated into the upcoming strategy development phase.

The plans will revitalize Kaplan Arena and establish a new state-of-the-art Sports Performance Center.

That natural, bee-produced sweetener you stir into your tea and lavish on your toast may be laced with cesium-137.

U.S. Sen. Tim Kaine (D-Va.) LL.D. ’06 will join William & Mary Chancellor Robert M. Gates ’65, L.H.D. ’98 for a discussion on “Crucibles of Leadership: U.S. Foreign Policy Past, Present and Future” at the Sadler Center’s Commonwealth Auditorium Feb. 6.

William & Mary has signed a power purchase agreement with Dominion Energy that will source nearly 50% of the university’s electricity from renewable energy.

The leaders of William & Mary’s Institute for Integrative Conservation envision their nascent enterprise as a smooth pathway to the empowerment of students with the knowledge and skills to engage in the knotty environmental issues of the 21st century.

Grace Solini, a member of William & Mary’s class of 2020, will receive the Thomas Jefferson Prize in Natural Philosophy.

"Priests of the Law: Roman Law and the Making of the Common Law’s First Professionals," reflects William & Mary Law Professor Thomas J. McSweeney’s background as both legal scholar and historian.

Leslie Cochrane, senior lecturer of English and linguistics at William & Mary, will be awarded the 2020 Thomas Jefferson Teaching Award at a Jan. 29 ceremony.

For Kathryn Monfalcone '20, serving her community has been instinctual.

Heather Macdonald, Chancellor Professor of Geology at William & Mary, will be awarded the 2020 Thomas Jefferson Award at a Jan. 29 ceremony.

Road to Richmond, sponsored by the W&M President’s Office and the Office of Government Relations, offers students a platform to represent their interests before members of the Virginia General Assembly.

Tanner Braman '20, a senior from Seattle, has been picked as this year’s student speaker for Charter Day.

Attendees can experience a wide variety of topics, sights and sounds during the spring semester's arts happenings at William & Mary.

The second oldest institution of higher education in the United States and oldest university in Scotland broaden relationship with new summer study abroad program.

Tommy Orange, author of bestselling novel "There There," is scheduled to visit W&M's campus Thursday and Friday.

The bottle was recovered as part of an archaeological dig at the Civil War-era site of Redoubt 9, which today is more commonly known as exits 238 to 242 of I-64 in York County.

Comedian Jaboukie Young-White, a correspondent for “The Daily Show with Trevor Noah,” will perform at William & Mary.

As part of the university’s ongoing sustainability efforts, William & Mary Dining Services implemented a phase-out to use up its remaining stock of single-use plastics on the way to switching to alternatives.

William & Mary will honor the new executive director of the Jamestown-Yorktown Foundation, a former U.S. ambassador and a former rector of the university during its 2020 Charter Day ceremony.

The study confirms that poultry wastewater inhibits microbes’ capacity to remove nitrogen.

William & Mary alumna Evin Dogu '02 envisions Sub Rosa as more than just a bakery, but also a community gathering place.

The Japanese swordsmiths didn’t discuss the secrets of their craft and neither does the brown recluse spider.

In U.S. News & World Report’s Best Online MBA Program rankings, William & Mary’s Raymond A. Mason School of Business jumps to 28th overall and ranks even higher for veterans, coming in at 22nd.

With the help of local volunteers ranging from children to retirees, the camp gave 14 kids on the autism spectrum the chance to not just gain tennis skills, but to build connections — and confidence.

Inga Carboni, an associate professor at William & Mary's Raymond A. Mason School of Business, is the author of 2019’s “Connect the Dots How to Build, Nurture, and Leverage Your Network to Achieve Your Personal and Professional Goals.”

The 13th annual W&M Global Film Festival will feature films from around the world, including many influenced by William & Mary graduates.

Kristen Popham '20 and Government and American Studies Professor Simon Stow co-authored a chapter for an upcoming book titled "The Cold War and American Life."

Yusef Salaam of the Exonerated Five, formerly known as the Central Park Five, will speak at William & Mary’s 2020 Martin Luther King Jr. commemoration on Jan. 30.

Merging the grueling physical and competitive aspects of sports with their religious faith makes athletics the perfect arena in some respects for evangelical Christians, contends William & Mary Associate Professor of Religious Studies Annie Blazer.

A new study in Nature provides an unprecedented, decade-long global view of the vertical migration of zooplankton.

$1.5 million gift to fund scholarships at William & Mary’s Raymond A. Mason School of Business.